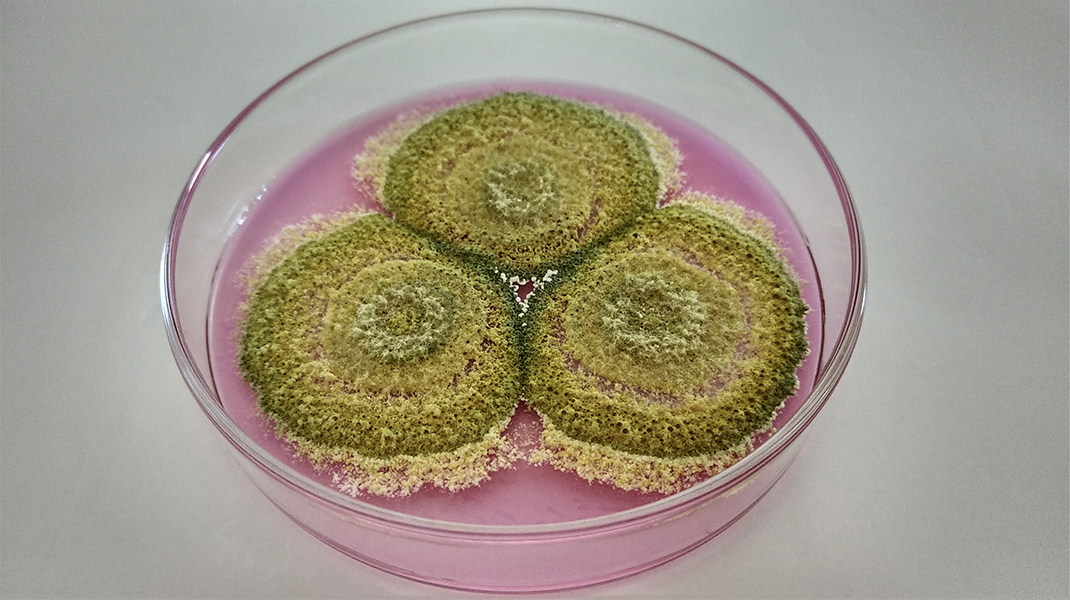

Seguinos en las redes
Buscanos en las redes para mantenerte actualizado sobre nuestros productos e investigaciones.
Mycotech® | Inscripta en el Servicio Nacional de Sanidad y Calidad Agroalimentaria SENASA como elaborador de fertilizantes y productos biológicos - Planta Biológica N° 0098